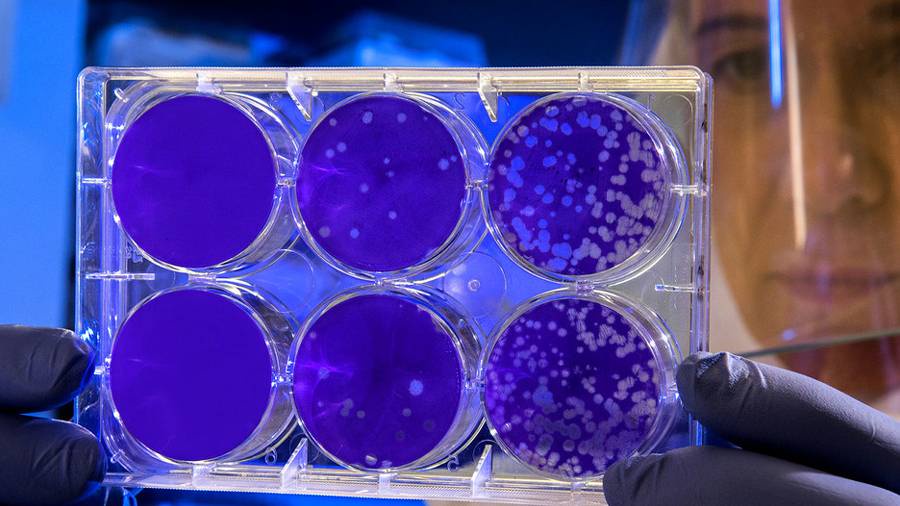

Фото СДС
О появлении нового варианта вируса SARS-CoV-2 британские власти уведомили ВОЗ 14 декабря, сообщив, что в нем был выявлен ряд генетических изменений. По состоянию на 13 декабря 2020 года в Англии было зарегистрировано в общей сложности 1108 случаев коронавируса нового образца, в основном на юго-востоке страны.
Ученые в Соединенном Королевстве, как сообщают британские власти, в срочном порядке проводят ряд дополнительных эпидемиологических и вирусологических исследований с целью дальнейшего определения последствий любого изменения в свойствах вируса, в том числе в плане его передачи, тяжести течения заболевания, иммунного ответа организма или эффективности вакцины.
«Новому варианту вируса, выявленному в Соединенном Королевстве, присущи несколько комбинаций мутаций, особенно в гене S, и наблюдаются первые признаки того, что этот вариант, вероятно, может легче передаваться от человека человеку», – отмечается в заявлении ВОЗ. Его авторы отмечают, что сегодня крайне важно адаптировать системы тестирования к мутированному вирусу, сообщает Служба новостей ООН.
Эксперты ВОЗ пока не могут сказать, будет ли новая вакцина эффективной против нового штамма, выявленного в Великобритании. Они призывают не строить догадки, а дождаться результатов исследования ученых.
В ВОЗ считают, что дальнейшая циркуляции вируса COVID-19 cкорее всего «приведет со временем к появлению многочисленных новых мутаций». Именно поэтому эксперты призывают своевременно выявлять любые новые варианты вируса и, в частности, увеличить объемы секвенирования вирусов SARS-CoV-2, обмениваться данными об их последовательностях на международном уровне и сообщать о случаях обнаружения мутаций.
«Очень важно остановить распространение вируса у его источника. Необходимо оставить в силе все основные санитарно-противоэпидемические и ограничительные меры, доказавшие свою эффективность», – подчеркивают в ВОЗ.
Эксперты организации уверены, что чем больше людей пройдут вакцинацию, тем в большей степени снизится циркуляция вируса, а вследствие этого уменьшится и потенциальная возможность появления новых мутаций и вариантов.